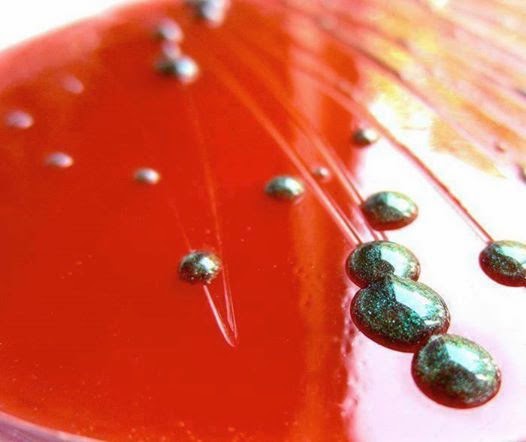
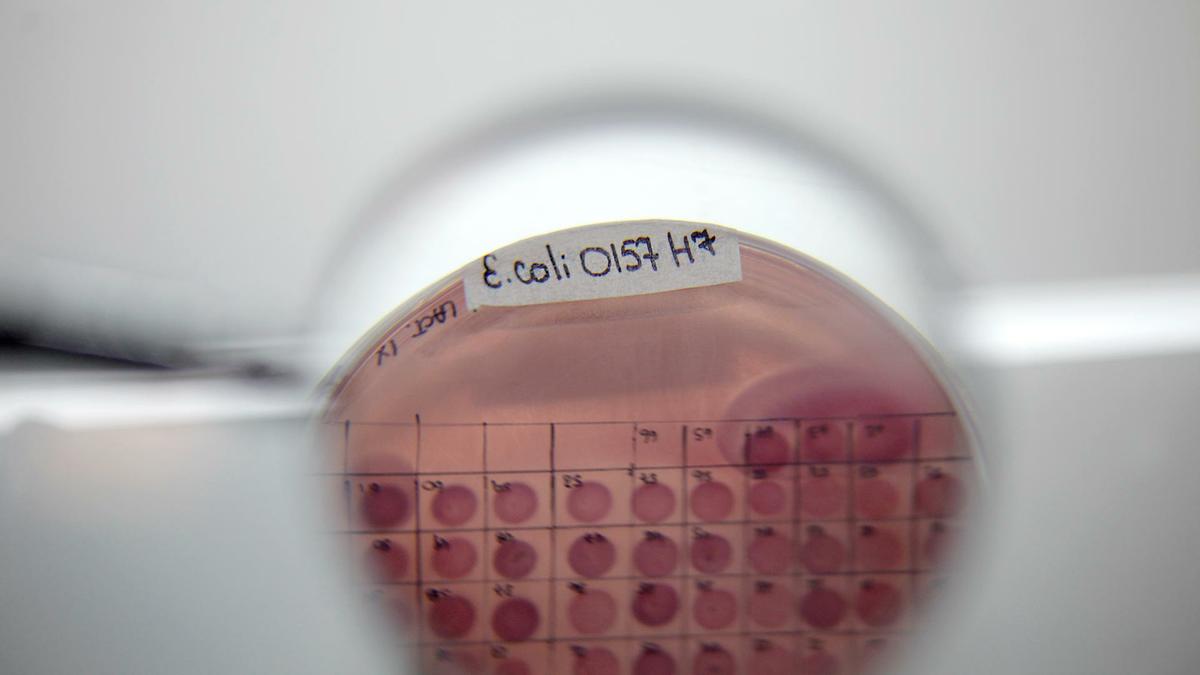

Escherichia coli Enterohemorragica o Verotoxigénica (eceh) (cie- 10 a04.3) Síndrome Urémico Hemolítico (SUH)
Los alimentos, para que se consideren de buena calidad higiénica, deben estar exentos de microorganismos peligrosos, pero en general no es posible examinar los productos o alimentos para investigar la presencia de todos y cada uno de tales organismos.
Esto se puede resolver determinando organismos indicadores, como coliformes y enterococos. Por lo que se refiere a los coliformes, la presencia de E. coli en un alimento indica generalmente una contaminación de origen fecal. Así E. coli es un indicador clásico de la presencia de patógenos entéricos en agua, moluscos, productos lácteos y otros alimentos. Es un microorganismo emergente que causa dos patologías: Diarrea Hemorrágica y Síndrome Urémico Hemolítico (SUH), uno de cuyos agentes causales fue comunicado en 1983. En los alimentos la presencia y concentración de E. coli es de menor significado y su presencia, incluso en mayor número, no implica necesariamente una contaminación fecal intensa reciente.
Su número está influenciado por muchos factores como crecimiento actual en el alimento, equipo deficientemente sanitizado y contaminación a partir de las personas. Por lo tanto todo lo que puede concluirse con muchos alimentos es que la contaminación fecal, directa o indirecta, tuvo lugar en alguna fase de su obtención y que la seguridad sanitaria del alimento es cuestionable. Escherichia coli enterohemorrágico o verotoxigénico (EHEC), produce citotoxinas (verotoxinas o shigatoxinas tipo 1 y 2), enterohemolisina, factores de adherencia intestinal. Es un microorganismo ácido tolerante, cuyos principales serotipos son: O157:H7, O26:H11, O111:H8, O103:H2, O113:H21 y O104:H21. La dosis infectante es muy baja, alrededor de 3 - 15 bacterias/g alimento.
Tiene distribución universal. El ganado bovino es el principal reservorio. La prevalencia oscila entre 1-10 % y es mayor en terneros. ECEH puede sobrevivir en el medio ambiente unos días y en el agua varios meses. La transmisión es por la contaminación fecal de los alimentos (carne vacuna picada o molida insuficientemente cocida, salame, leche, frutas y verduras crudas [brotes de alfalfa], jugo de manzana, mayonesa, yogour), el agua y la contaminación cruzada de estos alimentos.
La transmisión directa, persona-persona por la vía fecal - oral ocurre en el hogar y en instituciones semicerradas. Afecta todos los grupos de edad, pero, en los niños menores de 10 años la enfermedad es más grave. Un factor de riesgo es la hipoclorhidria. La excreción de E. coli persiste durante 1-3 semanas.
EHEC ha causado epidemias de enfermedad diarreica aguda. La primera epidemia por E. coli O157:H7 ocurrió en el año 1982 donde la fuente de infección fueron las hamburguesas con cocción insuficiente de una cadena de restaurantes de comidas rápidas. El primer brote de enfermedad por E. coli O157:H7 transmitida por el agua de una red pública se produjo entre diciembre 1989 y enero 1990. La primera epidemia de infección por por E. coli O157:H7 por agua recreacional (piscinas), tuvo lugar en 1993; el primer brote por bebida (sidra de manzana) ocurrió en 1991 (n=23) en Canadá.
Una epidemia afectó a cuatro estados (Estados Unidos) en 1993; el alimento involucrado fueron hamburguesas de una cadena de comidas rápidas y hubo diseminación secundaria persona a persona y un alimento inusual, salame provocó un brote en 1994. La carne insuficientemente cocida ha provocado y provoca la mayor cantidad de brotes. La EHEC disrumpe las microvellosidades y se adhiere a los enterocitos. La verotoxina tiene como receptor los glucolípidos globoseries (globotetraosilceramida) de la superficie celular e inhibe la síntesis proteica. El período de incubación es de 2-8 días (promedio 3-4 días).
Cursa con diarrea acuosa, diarrea sanguinolenta, colitis hemorrágica, síndrome urémico hemolítico (SUH) y púrpura trombocitopénica. En la enfermedad diarreica aguda el dolor cólico abdominal es frecuente en los niños y en los ancianos; los vómitos ocurren en el 30-50 % de los casos asociados con la diarrea acuosa.
La diarrea dura 3-4 días (rango 3-10 días). El 33 % de los pacientes requiere internación. El SUH se puede presentar en los pacientes con diarrea sanguinolenta. Durante la enfermedad debe evitarse el contacto con los enfermos. Deben cumplirse las prácticas que corresponden al aislamiento entérico. Las personas infectadas deben ser excluidas de la manipulación de alimentos así como también de la atención de niños hasta tener dos cultivos de heces negativos. En su momento fué una gran connotación periodística el impacto sanitario producido por la contaminación de cierto grupo de alimentos por el agente Escherichia coli enterohemorrágica (EHEC).
En particular, nos referiremos al denominado Síndrome Urémico Hemolítico o Síndrome de Gasser. Mucho se ha dicho y escrito, pero entendemos que la bibliografía científica utilizada, perteneciente a destacados profesionales nacionales de la Salud Pública, es de excelencia y la más adecuada para la elaboración de este informe. Resulta interesante destacar que en las primeras observaciones, en la década del 50 y del 60, surgen interpretaciones tanto clínicas como etiológicas y patogénicas, que luego fueron desplazadas por otras o relegadas al olvido para cobrar nuevamente vigencia en la actualidad enriquecidas con estudios y observaciones de los últimos años. En 1966 (Voyer y Walther, 1966), no hacían diferenciación entre la Púrpura Trombótica Trombocitopénica (PFT) y el SUH más que por la edad de presentación y la extensión de las lesiones. Considerábamos los términos de PTT y SUH dentro de una vasta nomenclatura para referencia a variables sintomáticas, como veremos más adelante.
Posteriormente se desvinculó a estas entidades, diferenciando netamente por un lado la PTT o Síndrome de Moschcowitz Symmer de presentación especialmente en jóvenes adultos con sintomatología predominantemente neurológica, lesiones microvasculares diseminadas, evolución generalmente fatal y etiología desconocida y por otro el SUH o Síndrome de Gasser de presentación principalmente en niños de corta edad, precedido generalmente por diarrea sanguinolenta.
Por ello se postuló que SUH y PTT pueden ser gradientes sintomáticas de una misma enfermedad (Remuzzi, 1987) referida genéricamente como Microangiopatía Trombótica (MAT, Kaplan, 1995) término acunado por Habib. Sin embargo, la similitud entre la PTT y las formas graves de SUH con daño neurológico por lesiones extrarrenales, no significa una identidad entre ambos cuadros (Kaplan, 1995). En 1955 Gasser, en Suiza, describe 5 casos, 4 de los cuales eran lactantes e introduce la denominación de Síndrome Hemolítico Uremígeno. También se han utilizado denominaciones como Acroangiopatía Trombocítica, Trombopatía Plaquetaria Difusa y Acroangiotrombosis Verrugosa Trombopénica (Debré y Mozziconacci, 1958).
Toda la nomenclatura estuvo así basada en las alteraciones hematológicas y las lesiones microvasculares de trombosis. En 1962, Gianantonio presenta en la Sociedad Argentina de Pediatría 47 observaciones del Hospital de Niños Ricardo Gutierrez de Buenos Aires, recopiladas desde 1957, a lo que suma posteriormente nuevos casos. En los años 1963 y 1964 los uruguayos hacen sus primeras observaciones. Garrahan, en la 1ra. Cátedra de Pediatría refiere 15 casos y en el interior del país, López Pondal, 3 a los que deben sumarse otros dos observados también en Tucumán por el Dr. Eduardo Martínez. Publicaciones de centros asistenciales de todo el país muestran el interés que ha despertado esta enfermedad entre nosotros y el incremento continuo de su incidencia que hace de la Argentina la zona endémica más afectada del mundo. La casuística acumulada hasta la fecha es de más de 7.000 casos, lo que supera a lo observado en todo el resto del mundo. En la década del 80 se intenta también el tratamiento con factores antiagregantes plaquetarios como aspirina y dipiridamole (O"Regan y col., 1980) y se destacan alteraciones anatomopatológicas presentes en diversos órganos a más de las ya bien caracterizadas lesiones renales, destacándose especialmente las lesiones cerebrales y pancreáticas (Upadhyaya y col., 1969, Preimhak y col., 1984).
En tanto en la década del 60, en la búsqueda etiológica predominaban las referencias de asociaciones con infecciones virales, a fines de la década del 70 se comunican asociaciones con infecciones por enterobacterias, iniciándose con las observaciones de Shigellosis en Centro América y luego en la India. En este país Ragupathv refiere una fuerte asociación con la Shigella disentería tipo 1. Hoy en día se presenta así el estudio de toxinas liberadas por enterobacterias, como la línea más promisoria para la comprensión epidemiológica de la enfermedad en su presentación endémica tanto en los casos esporádicos como epidémicos. Hasta ahora esto se ha referido a la Shiga-like toxina producida por cepas de E. coli y a la toxina Shiga producida por la Shigella disentería tipo 1 y ocasionalmente por la Shigella flexneri, como también lo observamos nosotros, pero parece ser también extensivo a otras citotoxinas producidas por bacterias como Clostridium difficile, Yersinia enterocolítica y Campilobacter.
El SUH es la causa más frecuente de insuficiencia renal aguda (IRA) en los niños (en la mitad de los casos necesita diálisis). Es un síndrome que incluye IRA, trombocitopenia (disminución del número de plaquetas en la sangre) y hemólisis (destrucción de los glóbulos rojos que lleva a una anemia). Es producido, en la mayoría de los casos, por toxinas producidas por una bacteria: Escherichia coli O157:H7. La toxina producida por este serogrupo de E coli se denomina "shiga toxina", por ser similar a la producida por Shigella. La muerte por síndrome urémico hemolítico disminuyó gracias a la precocidad de los diagnósticos y a los nuevos métodos de control de la insuficiencia renal.
Hoy, la tasa de letalidad es del 2 por ciento. Según datos del Comité Nacional de Nefrología, el 70 por ciento de los niños que padecen esta enfermedad se recuperan sin secuelas, sin embargo, es necesario controlarlos regularmente porque, en algunos casos, desarrollan problemas renales o hipertensión como consecuencia tardía del síndrome. Escherichia coli O157:H7 y otros serotipos de E. coli productor de toxina Shiga (STEC: Shiga Toxin E. coli). E.coli O157:H7 es un patógeno emergente asociado a enfermedades transmitidas por alimentos. En 1982 fue reconocido por primera vez como patógeno humano responsable de dos brotes de diarrea sanguinolenta severa que afectaron a 47 personas en EE.UU. Los brotes fueron asociados epidemiológicamente con hamburguesas contaminadas, consumidas en restaurantes pertenecientes a una cadena de comidas rápidas. A partir de entonces numerosos brotes han sido notificados en distintas partes del mundo. Hoy se sabe que E. coli O157:H7 es el prototipo de un grupo de más de 150 serotipos de E. coli (O26:H11; O103:H2; O111:NM; O113:H21; O145:NM; entre otros) que comparten el mismo potencial patogénico. Los serotipos de STEC (Calderwood y col., 1996), asociados a enfermedades severas en el hombre pertenecen a la categoría de E. coli enterohemorrágico (EHEC: enterohemorrhagic E. coli).
Los serotipos de la VTEC (Vero Toxygenic Escherichia coli) asociados a la producción de enfermedad en el hombre son los que corresponden a la clasificación de enterohemorrágicos (EHEC). Esta designación alude a su capacidad de producir lesiones hemorrágicas en el intestino. Este grupo posee una serie de cualidades que determinan su virulencia, entre las cuales cabe mencionar:
a. Producen verocitotoxina (VT1, VT1 ? VT2, VT2 y sus variantes).
b. Sintetizan una proteína llamada intimina, que es codificada por el gen llamado eaeA del cromosoma de la bacteria. La intimina es la responsable de la unión de E. coli a las células de la pared intestinal (enterocitos) proceso que inicia las lesiones en las vellosidades que los enterocitos poseen en aquella parte de su superficie que constituye la pared interna del intestino.En algunos casos de SUH se han aislado cepas de VTEC que carecen del gen eaeA en los que la unión a los enterocitos está reemplazada por la producción de otro accesorio de adherencia.
c. Poseen un plásmido (esto es, ADN de doble cadena que al unir sus extremos adquiere forma circular) de gran tamaño (por eso se lo llama megaplásmido) con un peso molecular de 60 millones. Este plásmido contiene los genes necesarios para la síntesis de una enterohemolisina, toxina que es capaz de producir la destrucción (lisis) de los glóbulos rojos (de allí hemolisina) y un apéndice de adherencia al epitelio intestinal típico de las EHEC.
Drummond en 1989 y Kaplan en 1990 clasificaron al SUH de acuerdo a su etiología. Una división importante es la que considera como SUH típico al que presenta antecedentes de diarrea (D+), asociado a infección por gérmenes productores de Stx, forma endémica en nuestro país. El SUH atípico es el que no presenta diarrea en sus pródromos (D-). El origen del SUH post-entérico ha sido investigado en los últimos 15 años. A fines de la década del 70, Konowalchuk y col. informaron que algunas cepas de E. coli producían ciertas exotoxinas (a las que llamaron verotoxinas por su acción sobre las células Vero) relacionadas a la proteína de 70 kDa codificada en el DNA de Shigella dysenteriae tipo 1.
El significado clínico de estas toxinas permaneció desconocido hasta que, en 1983, Riley y col. informaron una asociación entre la infección por E. coli serotipo O157:H7 y dos brotes de colitis hemorrágica; y Karmali y col. demostraron infección por STEC en 11 de los 15 casos de SUH aislados. Luego, la asociación entre SUH e infección por STEC, particularmente cepas del serotipo O157:H7, fue confirmada por numerosos estudios realizados en diferentes países (Griffin y Tauxe, 1991) incluyendo Argentina (Novillo y col., 1988; López y col., 1989; Rivas y col., 1996). Se ha estimado que, en América y en Europa, alrededor del 90% de los niños con SUH tiene alguna evidencia de infección por STEC siendo el serotipo O157:H7 responsable del 70% de los casos (Lior y col., 1994; Caprioli y col., 1994; Van de Kar y col., 1994). En Argentina, la asociación entre SUH y STEC del serotipo O157:H7 no está suficientemente clarificada. López y col. encontraron que el serotipo O157:H7 no es común en niños argentinos con diarrea inducida por toxina Shiga complicada o no con SUH. En cambio, Rivas y col. detectaron en niños con SUH fundamentalmente cepas de E. coli del O157:H7.
Es importante recordar que el primer aislamiento de E. coli O157:H7 fue realizado en nuestro país, en 1977, a partir de terneros con colibacilosis (Orskov y col.). La información sobre STEC proviene fundamentalmente de estudios realizados con cepas del serotipo O157:H7, fácilmente distinguible de otros serotipos de E. coli por sus peculiares propiedades bioquímicas, ya que no fermentan sorbitol o lo hacen lentamente (Farmer y Davis, 1985) y no poseen actividad de ßglucuronidasa (Thompson y col., 1990).
Escherichia coli forma parte de la flora habitual del intestino del hombre y de los animales. Los animales domésticos, especialmente los rumiantes, constituyen el principal reservorio natural de STEC. La prevalencia en vacunos oscila entre 0,1 y 16%. Ha sido aislado también de heces de gansos, ovinos, equinos, perros, cabras y ciervos. Estudios realizados en EE.UU., Canadá e Inglaterra (Wells y col., 1991; Chapman y col., 1993) han identificado al ganado bovino como un reservorio importante de E. coli O157:H7, luego que los primeros brotes de colitis hemorrágica estuvieron asociados al consumo de hamburguesas mal cocidas y leche cruda, (Griffin y Tauxe, 1991).
STEC ha sido aislado de las heces y aparentemente habita el tracto intestinal del animal portador (Sanderson y col., 1995). El ganado lechero y particularmente los terneros y vaquillonas serían portadores más frecuentes que el ganado adulto. También fue aislado del ganado de carne, específicamente de terneros con diarrea, en donde STEC no sería el causante de esta patología. En 1987, una cepa con estas características se aisló de terneros con colibacilosis en Argentina (Ørskov y col., 1987).
En estudios realizados en 720 animales sanos de seis especies diferentes, STEC fue aislado en materia fecal de 208 animales (28,9%). La prevalencia fue mayor en tres especies de rumiantes: ganado bovino (21,1%), ovejas (66,6%)y carneros (56,1%). Fue detectado más esporádicamente en no rumiantes: pollos (<0,799), cerdos (7,5%), perros (4,8%) y gatos (13,8%) (Beutin y col., 1993). Recientes investigaciones confirman que los terneros son reservorios de la bacteria Escherichia coli O157H:7, causante de enfermedades en humanos.(UNL (Universidad Nacional del Litoral) - Profesor Dr. José Luis Otero et al).
A partir de un estudio de caracterización de E. coli O157:H7 aislados a partir de terneros, se confirmó que es "importante el papel del ganado bovino en la epidemiología de las enfermedades producidas por este agente patógeno en el hombre" y que "las cepas aisladas de ganado poseían todos los factores de virulencia necesarios para producir enfermedad en humanos".
Existen también diferencias geográficas en la incidencia del SUH y su forma de presentarse. En particular, en la Argentina no han ocurrido brotes de magnitud semejante a los de EE.UU. y la estadística señala más bien la aparición de numerosos casos esporádicos. Contrariamente a lo esperado, el síndrome urémico hemolítico, se presenta en niños de hogares con un buen nivel socioeconómico.
Si bien se registran casos durante todo el año, su frecuencia aumenta en la primavera, alcanzando un máximo durante el verano, para luego decrecer hacia el otoño. La carne picada, insuficientemente cocida, y los lácteos y jugos sin pasteurizar como el vehículo más frecuente de brotes de ETA (Enfermedades Trasmitidas por Alimentos) causados por este organismo. La colitis hemorrágica ha sido transmitida además por embutidos fermentados, leche cruda, yogures artesanales, sidra de manzana y mayonesa. Los brotes que han involucrado alimentos ácidos demuestran la tolerancia de los organismos causales a pH bajos. Estos microorganismos también han sido aislados de productos vegetales, la contaminación de vegetales puede ser consecuencia del uso de abonos orgánicos de origen bovino. También el agua ha sido considerada vehículo de transmisión, habiéndose informado de brotes asociados a la ingestión de agua de bebida no clorada, o del contacto con piletas de natación y también de un lago contaminado. También se ha identificado a la materia fecal bovina como una fuente de contaminación para alimentos y agua.
No obstante, la dinámica de STEC, en su relación reservorio - medio ambiente, no está totalmente dilucidada. Actualmente se ha convertido en uno de los desafíos más fuertes para la industria de la carne. La transmisión persona a persona es también una vía importante para adquirir la infección debido a la baja dosis infectiva (50 ? 100 ufc). Ingresa al organismo por la ingesta de carne (especialmente mal cocida), o por otros alimentos que hayan estado en contacto con la materia fecal de la vaca, como leche no pasteurizada, verduras y frutas mal lavadas, aguas contaminadas, etc .
También la contaminación fecal de las aguas o la falta de higiene en el procesamiento industrial puede explicar la presencia de esa bacteria en los pescados. Es importante conocer el origen de los alimentos y en aquellos que los posean, leer muy bien los rótulos, cómo han sido conservados y procesados, observar la higiene, el cumplimiento de la cadena de frío y el grado de cocción. En esta situación lo más valioso es la prevención. La contaminación fecal del agua y otros alimentos y la contaminación cruzada durante la preparación de los alimentos son rutas importantes en la transmisión de la infección.
Es importante destacar que STEC sobrevive a las temperaturas de refrigeración y congelación y puede desarrollar a 8ºC (Palumbo y col., 1995). Esta característica tiene un tremendo impacto tanto en la industria de la carne, como en los sectores de comercialización en donde el uso del frío está muy extendido. Cepas de E. coli enterohemorrágica (EHEC) han sido aisladas de una gran variedad de alimentos y del medio ambiente, esto implica distintas condiciones en término de nutrientes, pH, salinidad y temperatura.Recientes brotes de diarrea y SUH han sido asociados al consumo de alimentos como el jugo de manzana, mayonesa y embutidos fermentados, alimentos de naturaleza ácida.
Si bien la carne vacuna resulta la principal fuente de contagio, el consumo de lácteos y jugos de fruta no pasteurizados o de verduras y agua contaminada (que hayan estado en contacto con las heces de los animales), también puede desencadenar la enfermedad.
Incluso, un estudio realizado en nuestro país sobre 34 pacientes con SUH y 95 convivientes demostró que el 24 % de los afectados tuvo, al menos, un familiar con diarrea. Para evitar la vía de contagio de persona a persona (la que se produce por el contacto con la materia fecal del enfermo), los especialistas insisten en la necesidad de lavarse las manos, con agua y jabón, luego de ir al baño y antes de manipular los alimentos.
Estas bacterias producen unas potentes citotoxinas que destruyen in vitro las células en cultivo de la línea continua llamada Vero (que proviene de células de riñón de mono verde africano) razón por la cual han sido bautizadas como verocitotoxinas. También se conocen como (SLT) Shiga-like toxins (toxinas parecidas a la Shiga), porque pertenecen a la misma familia que la citotoxina Shiga sintetizada por la bacteria Shigella dysenteriae tipo 1 causante de la disentería bacteriana.
La producción de verocitotoxinas está codificada por los ácidos nucleicos de distintos bacteriófagos, que son virus que infectan a las bacterias, los que incorporan instrucciones en Escherichia coli para sintetizar nuevos compuestos. Hay dos tipos de verocitotoxinas, las VT1 (SLT-I) y las VT2 (SLT-II) con sus variantes que incluyen a la VT2e, producida por las bacterias que causan la enfermedad de los edemas en el cerdo. Las verocitotoxinas ejercen su acción sobre una amplia variedad de células endoteliales que tapizan el interior de los vasos sanguíneos y sobre células epiteliales, incluyendo aquellas que tapizan el interior del íleon (parte final del intestino delgado) y colon (intestino grueso), células endoteliales glomerulares.
También actúan sobre los glóbulos rojos que presentan en su membrana el grupo glicolipídico P1. Las verocitotoxinas actúan sobre las células uniéndose específicamente a componentes de la membrana celular llamados receptores. Se sabe ahora que estos receptores son glicolípidos (componentes de la membrana celular formados por lípidos y azúcares) específicos.
El receptor habitual para VT1 y VT2 es una ceramida trihexosida llamada Gb3; la VT2e puede unirse a un glicolípido neutro diferente denominado Gb4. Las verocitotoxinas están formadas por dos subunidades llamadas A y B. La subunidad B es la encargada de asociar a la VCT con el glicolípido. Luego, la subunidad A de la toxina inicia la inhibición de la síntesis proteica en la célula llevando a la muerte celular por apoptosis (ver Ciencia Hoy, 53:12-21, 1999); la inhibición se produce por inactivación de la fracción llamada 60S de los ribosomas encargados de la síntesis de proteínas. Cuando esto sucede a nivel de las células que constituyen el endotelio de los vasos sanguíneos, el daño produce coagulación intravascular principalmente en el sistema nervioso central, el tubo digestivo y los riñones.
Queda también un bache importante. El control a nivel minorista, las llamadas "comida chatarra" y el problema de la venta callejera de alimentos. Estos son puntos críticos y no pueden ser dejados de lado si queremos hacer un intento de prevención fuerte para reducir el número de casos. No se han reportado casos de recurrencia en pacientes que han padecido SUH postentérico.
No se dispone aún de un tratamiento específico. El tratamiento de los pacientes con SUH en el período agudo es de mantenimiento. Se requiere atención sobre la hidratación, el balance de electrolitos, el adecuado aporte calóricoproteico, el tratamiento de la anemia y la diálisis peritoneal en los casos severos de oliguria y anuria. Durante la diarrea está contraindicado el uso de agentes que reduzcan la motilidad intestinal.
Por lo tanto, hasta que no se realice un estudio multicéntrico, randomizado, que demuestre la eficacia del tratamiento, se aconseja no suministrar antibióticos durante el período prodrómico o de estado. Se halla en fase de prueba un producto capaz de fijar e inactivar la Stx en la luz intestinal constituido por un oligosacárido sintético, con estructura similar al receptor natural de la citotoxina adherido a diatomeas (Synsorb-PK). También se encuentran avanzados estudios de humanización de anticuerpos murinos a Stx.
Medidas de prevención:
? Asegurar la correcta cocción de la carne; la bacteria se destruye a los 70º C. Esto se consigue cuando la carne tiene una cocción homogénea cuando no quedan partes rojas).
? Tener especial cuidado con la cocción de la carne picada.
? Utilizar distintos utensilios de cocina para cortar o tomar la carne cruda y la carne una vez cocida (Contaminación cruzada indirecta)
? Evitar el contacto de las carnes crudas con otros alimentos; tener en cuenta cómo se disponen dentro de la heladera y en mesadas. (Contaminación cruzada directa).
? Consumir leche, derivados lácteos y jugos de frutas pasteurizados y conservar la cadena de frío
? Lavar cuidadosamente las verduras y frutas.
? Asegurar la correcta higiene de las manos (deben lavarse con agua y jabón), antes de preparar los alimentos y luego de ir al baño como mínimo.
? Se sugiere que los menores de 2 años no ingieran comidas rápidas.
? Respetar la prohibición de bañarse en aguas contaminadas. Concurrir a piletas de natación habilitadas para tal fin.
? Consumir agua potable. Ante la duda, hervirla y agregar lavandina concentrada. Por este motivo, se aconseja consumir agua potable o de lo contrario; hervir agua en un recipiente limpio y tapado de tres a cinco minutos y no más; dejar enfriar el agua y conservarla en el mismo recipiente o agregar dos gotas de lavandina concentrada por cada litro de agua y esperar 30 minutos para ser consumida.
? Ante cualquier duda o síntoma, consultar al médico o dirigirse al centro de salud más cercano a su domicilio.
Hasta el momento no se dispone de una vacuna humana efectiva. Se hallan en etapa de desarrollo la producción de vacunas para prevenir la infección por STEC. Existen distintas vacunas candidatas basadas en:
a) utilización del lipopolisacárido bacteriano como inmunógeno;
b) toxoides de Stx;
c) utilización de cepas mutantes atóxicas;
d) la inserción de la subunidad B de Stx en una cepa de Vibrio cholerae como vector.
Vacunas desarrolladas utilizando toxoides han demostrado ser efectivas en prevenir las enfermedades relacionadas a STEC en animales. El consumidor debe saber que las cepas VTEC, además de ser capaces de crecer en ambientes muy ácidos (pH 2,5 a 3,0), pueden multiplicarse a temperaturas tan bajas como 7ºC (la temperatura habitual de una heladera) y mantenerse viables durante meses en carne congelada a - 20ºC (la temperatura habitual de un freezer de uso doméstico). En cambio, las bacterias se inactivan fácilmente por calentamiento. Esto justifica recomendar que durante la cocción de la carne la temperatura en su interior no deba ser inferior a 68ºC y que se debe evitar la ingestión de alimentos cárneos excesivamente rojos y jug